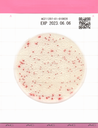
Easy Plate AC

Easy Plate AC
- 1x100 Placas/Paquete
Operación sencilla, resultados confiables - Certificación AOAC PTM
- Alta precisión
- Listo para usar, coloque una suspensión de muestra en la placa y comience la incubación.
- Muy poco espacio de incubación y residuos reducidos
Autodifusible, preciso, Certificado (AOAC-PTM, NordVal, MicroVal), REDUCE el espacio, el tiempo y el desperdicio.
Para Cuenta Aerobia (Cuenta Total)
Easy Plate AC es un dispositivo de cultivo microbiológico compuesto por una lámina impermeable, un medio seco preparado sobre la lámina y una cubierta transparente sobre el medio. El método Easy Plate AC está destinado a indicar el nivel de bacterias aeróbicas en productos alimenticios como una alternativa a los métodos microbiológicos (método oficial AOAC 966.23 y capítulo 3 del Manual de análisis bacteriológico de los funcionarios de alimentos y medicamentos de EE. UU.).
Es compacto, fácil de usar y reduce la cantidad total de desechos producidos durante las pruebas. El método Easy Plate AC ha recibido la certificación AOAC Research Institute Performance Tested Methods SM (041302) para carne de res cruda, carne molida cruda, rosbif, carne de cerdo molida cruda, cerdo chino a la barbacoa, tocino, jamón, salchicha de cerdo cocida, salchicha de Frankfurt, pollo crudo, pollo molido crudo, lechuga, arándanos, camarones crudos, salmón crudo, atún crudo, leche pasteurizada, queso natural y alimento seco para mascotas.
Durante la preparación de las placas para la incubación, no se requieren herramientas adicionales. Esto se debe al anillo hidrofóbico alrededor del área de cultivo, que ayuda a la distribución automática de la muestra en el área de cultivo.
1x100 placas/Paquete
Microorganismos objetivo: bacterias aeróbicas
Número de artículo: 61980
Tiempo de incubación: 48 horas +/- 2 horas
Temperatura de incubación: 35 °C +/- 1 °C
Vida útil: 18 meses después de la fabricación
Almacenamiento: 2-8 °C
Prepare la muestra según el manual.
Extraiga 1 ml de solución de muestra con una pipeta y abra la tapa de la placa. Pipetee la solución de muestra sobre la placa y cierre la tapa.
Incube según el manual.
https://hyserv.sharepoint.com/:v:/s/Server/EeyU2zJ7ceJJkeQxGoG8NjQBPOcGieK7u9zhmZbmQC-L-g?e=hPABt8
- Easy Plate AC AC20260302A exp 01.09.2027.pdf
- Easy Plate AC AC20260123A exp 22.07.2027.pdf
- Easy Plate AC AC20260120A exp 19.07.2027.pdf
- Easy Plate AC AC20260116A exp 15.07.2027.pdf
- Easy Plate AC AC20251226A exp 25.07.2027.pdf
- Easy Plate AC AC20251223A exp 22.07.2027.pdf
- Easy Plate AC AC20251218A exp 17.06.2027.pdf
- Easy Plate AC AC20251217A exp 16.06.2027.pdf
- Easy Plate AC AC20251216A exp 15.06.2027.pdf
- Easy Plate AC AC20251210A exp 09.06.2027.pdf
- Easy Plate AC AC20251021A exp 20.04.2027.pdf
- Easy Plate AC AC20251003A exp 02.04.2027.pdf
- Easy Plate AC AC20251002A exp 01.04.2027.pdf
- Easy Plate AC AC20251001A exp 31.03.2027.pdf
- Easy Plate AC20250924A exp 23.03.2027.pdf
- Easy Plate AC AC20250205A exp 04.08.2026.pdf
- Easy Plate AC AC20241203A exp 02.06.2026.pdf
- 61973_ AC202411126A.pdf
- 61973_ AC202411121A.pdf
- 61973_ AC20241031A.pdf
- 61973_ AC20241030A.pdf
- 61973_ AC20241029A.pdf
- 61973_AC20240906A .pdf
- 61973_AC20241003A .pdf
- 61973_AC20240906A.pdf
- 61973_AC20240826A .pdf
- 61973_AC20240823A .pdf
- 61973_AC20240918A .pdf
- Easy Plate AC AC20241003A exp 02.04.2026.pdf
- Easy Palte AC AC20240906A.pdf
- Easy Plate AC AC20240826A exp 25.02.2026 .pdf
- Easy Plate AC AC20240823A exp 22.02.2026 .pdf
- Easy Plate AC AC20240806A exp 05.02.2026.pdf
- Easy Plate AC AC20240726A exp 23.01.2026.pdf
- Easy Plate AC AC20240725A exp 24.01.2026.pdf
- Easy Plate AC AC20240626A exp 25.12.2025.pdf
- Easy Plate AC - AC20240604A - exp 03.12.2025.pdf
- Easy Plate AC AC20240531A exp 30.11.2025.pdf
- Easy Plate AC AC20240520A exp 19.11.2025.pdf
- Easy Plate AC AC20240319A exp 18.09.2025.pdf
- Easy Plate AC - AC20240228A - exp 27.08.2025.pdf
- Easy Plate AC - AC20240220A - exp 19.08.2025.pdf
- Easy Plate AC - AC20240216A - exp 15.08.2025.pdf
- Easy Plate AC - AC20240131A - exp 30.07.2025.pdf
- Easy Plate AC - AC20240130A - exp 29.07.2025.pdf
- Easy Plate AC - AC20240117A - exp 16.07.2025.pdf
- Easy Plate AC - AC20231229A - exp 28.07.2025.pdf